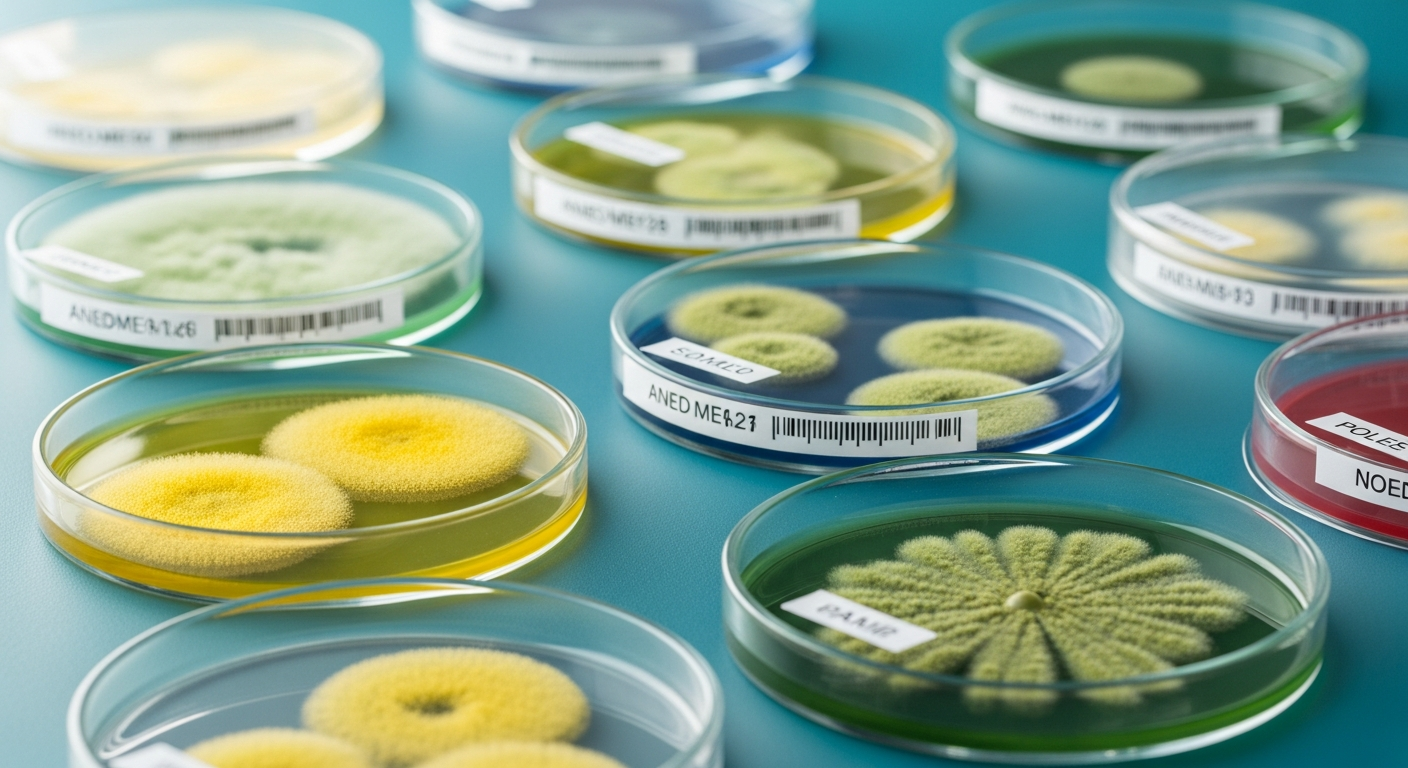
Mold Testing

Professional mold testing, air quality inspection, and protocol writing for homes across Southeast Michigan. Protect your family with certified experts you can trust.
Request A Free ConsultationWe test and document only. We never sell the repair — so you always get the truth, not a sales pitch.
Same-day scheduling, on-site thermal + air sampling, and certified lab results back within 72 hours.
Formal documentation accepted by insurers, attorneys, and real estate closing folders. Not just a report.
FLIR thermal camera, calibrated Bio-Pump air samplers, and expert lab analysis — every inspection.

24h
RUSH AVAILABLE
Licensed · Certified · Insured
Serving Southeast Michigan with certified inspectors, EPA-approved equipment, and air quality reporting that holds up in court. We don't just find mold — we give you the documentation to act on it.
Certified inspectors
$3M aggregate: GL, E&O & Pollution Liability
Accurate mold testing & inspection
Safe, effective remediation scopes
Same-day scheduling available
Real estate closing ready
Independent credentials that reinforce our testing-first approach and commitment to accurate, unbiased inspections.

Not feeling like yourself lately? Mold in your home or business may be the hidden cause. Nearly 47% of U.S. homes show signs of visible mold or mold odor, and exposure can create underlying health issues. When spores spread indoors, they contaminate the air you breathe and may trigger a variety of symptoms. Homeowners across Southeast Michigan often face hidden mold problems that, if left untreated, can lead to ongoing health concerns. Recognizing the signs early is the key to protecting your family and restoring safe indoor air quality.

Persistent headaches, tiredness, or trouble concentrating that may be connected to mold in your indoor air.

Sneezing, itchy eyes, and runny nose that may be linked to mold exposure and can feel like constant seasonal allergies.

Coughing, wheezing, or shortness of breath that could be from breathing in mold spores.

Rashes, itching, or dry patches that could be from coming into contact with mold or airborne spores.
Discover if your home is at risk for hidden mold in just 60 seconds. Our quick Spore Score Quiz gives you an instant risk rating and connects you with professional testing options if needed.
Get a personalized risk score for your home
Uncover hidden health risks caused by mold exposure
Takes less than a minute to complete
Free, fast, and secure
Mold Inspection & Testing
Full visual, thermal, and lab-certified mold assessment with written report and remediation protocol.

Visual Mold Inspection
FLIR thermal imaging and moisture mapping to identify hidden problem areas — fast first step.

Real Estate Mold Inspection
Same-day scheduling, 24-hour results, and Spore Shield Certified™ document for closing folders.

Comprehensive Mold Assessment
3D moisture mapping, 8 lab samples, HVAC inspection, and priority lab turnaround.

Post-Remediation Clearance
Independent clearance testing after remediation is complete — insurance-ready documentation.

Indoor Air Quality Testing
Certified air sampling for mold spores, allergens, and VOCs — results in 24–48 hours.

Commercial Mold Testing
Certified testing for offices, restaurants, and commercial buildings with insurance-grade docs.

Mold Remediation Protocol
Independent, unbiased scope of work document — take to any contractor for competitive bids.

Shield Status — Monitoring
Scheduled quarterly or annual air quality monitoring for property managers and facilities.
Specialized mold testing for Oakland County families. Independent, certified, and lab-backed — call today.
Mold has been linked to allergies, asthma, and brain fog. A test gives you peace of mind.
Mold may contribute to damage over time. Testing early can help save money.
Certified
MICRO CMI License
Free
Same-Day Consultation
$3M
Aggregate: GL · E&O · Pollution
We test. We don't remediate. No conflict of interest — ever.
Because we never perform repairs, our findings are 100% unbiased. We give you the truth — not a sales pitch.
Stay informed with expert tips on mold prevention and indoor air quality.
Find answers to frequently asked questions about our mold testing services and how we can help protect your home.
Independent mold testing for homeowners across the communities we serve.